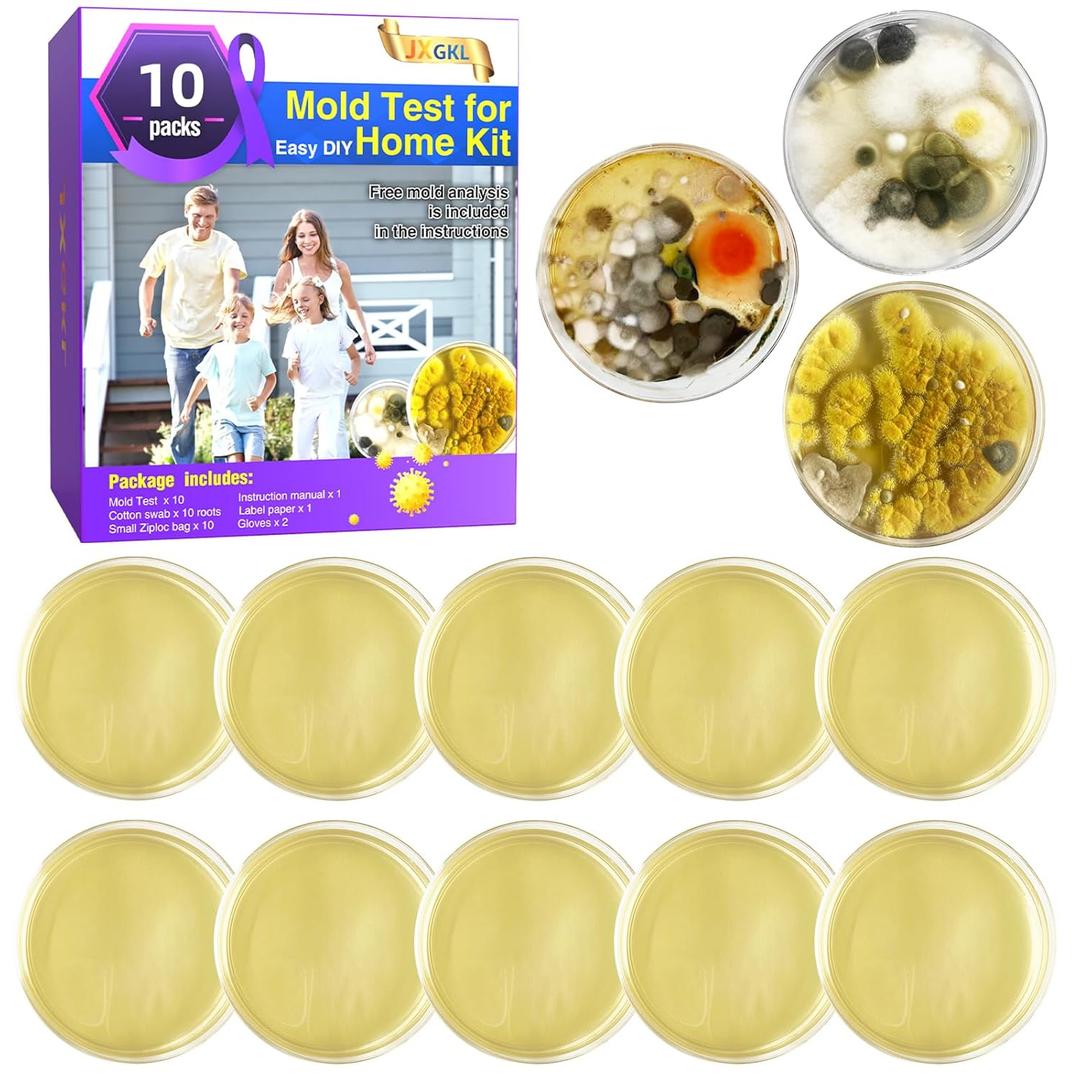
Mold Test for Home Kit,Home Mold Test,DIY Detector at Furniture,Wall Facing,Indoor Air Quality Testing Kits,Simple Detection Tests,air Tester,Black 26 Mold Testing, Home Mold Testing, Include Guide

Mold Test for Home Kit,Home Mold Test,DIY Detector at Furniture,Wall Facing,Indoor Air Quality Testing Kits,Simple Detection Tests,air Tester,Black 26 Mold Testing, Home Mold Testing, Include Guide
Condition: Appears New
Pickup Details
| Saturday, Jan 3 | 08:30AM - 02:00PM |
| Monday, Jan 5 | 11:00AM - 06:30PM (Appointment only) |
| Tuesday, Jan 6 | 12:00PM - 06:30PM |
| Wednesday, Jan 7 | 11:00AM - 06:30PM (Appointment only) |
Product Details
| SKU | OLARR5650718 |
| ASIN | B0DQXZMK79 |